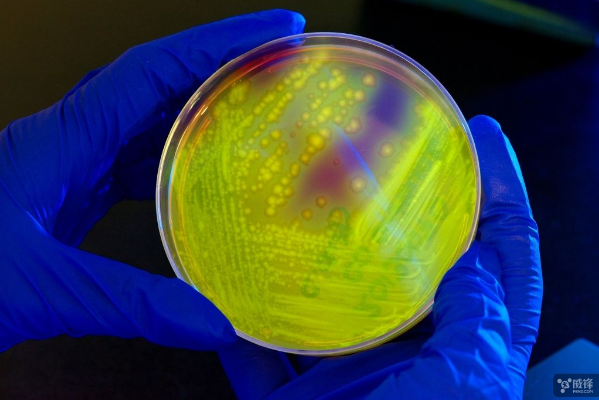

人类历史中,抗生素已经使用了很长一段时期。由于抗生素的未来现在越来越明显,医学界研究人员也正在寻求一种新的方法来代替它,而近日一项研究显示研究人员似乎已经找到了这种方法,即依靠 CRISPR 来代替抗生素。

来自俄罗斯斯科尔科沃科技学院和美国国立卫生研究所及麻省理工学院的联合科研团队发现了具有适应性细菌防御功能的新型 CRISPR-Cas 系统,此类系统可用于研发基因编辑及基因组检测新方法。该成果刊登在《Nature Reviews Microbiology》科学期刊上。
培养皿中的难梭状芽胞杆菌在长波紫外光下发光
CRISPR 是一种强大的基因编辑技术,目前已经被开发并用于确编辑人类基因以治疗一些疾病。研究人员在实验室中使用 CRISPR 来对抗艰难梭状芽胞杆菌(Clostridium difficile),这种细菌可能导致医院和疗养院的致命感染,同时还并被列入美国疾病控制和预防中心的紧急耐药性威胁之中。
研究人员发现,通过 CRISPR 向细菌病毒 DNA 基因中传递虚假信息,并加上称为 Cas 的 DNA 切片酶来识别和切断入侵噬菌体的基因,再用噬菌体来发送虚假消息给艰难梭状芽胞杆菌,从而让细菌削弱其 DNA 系统。为了做到这一点,实验室正在开发能够携带定制 CRISPR 信息的噬菌体,但在人体中噬菌体会很快被胃酸分解。为此研究人员计划将通过无毒细菌或者是益生菌作为噬菌体的载体。

使用 CRISPR 的好处在于,它能杀死一种有害细菌的同时还保留了有益细菌,相比之下,广谱抗生素杀死的是一大片不分好坏的细菌。科研团队目前正在进行了大量的生物信息分析工作,而这项研究在基因工程领域具有广泛的应用前景,目前课题组正详细研究该系统类型的特点,探索研发新型抗生素。新西兰奥塔哥大学微生物学家彼得·芬内兰(Peter Fineran)说:“在取代目前的抗生素之前,我们还有很长的路要走。”



